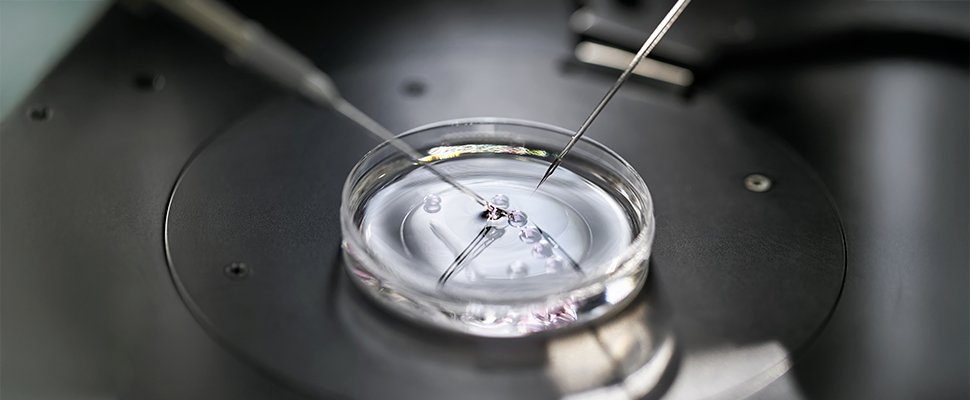

Atendimento exclusivo Ingámed/Inveq
onlineOlá, para que possamos iniciar uma conversa, por favor, preencha os dados abaixo.
aguarde.
Olá, fale com uma de nossas consultoras! Nosso time está pronto para atender você.
Tecnologia em Reprodução Assistida
Em um laboratório de reprodução humana assistida, cada etapa do processo exige precisão, controle e excelência técnica. Nesse contexto, monitorar indicadores de desempenho (KPIs) não é apenas uma boa prática — é uma necessidade. Acompanhar métricas bem definidas permite garantir a qualidade dos serviços, aumentar as taxas de sucesso dos tratamentos e otimizar os recursos laboratoriais.
Neste artigo, você vai conhecer os principais indicadores de desempenho para laboratórios de reprodução humana, entender como eles são aplicados no dia a dia e por que são fundamentais para a tomada de decisões estratégicas.

A fertilização in vitro (FIV) envolve diversas etapas complexas, como a coleta e preparação dos gametas, a fecundação, a cultura dos embriões e a transferência embrionária. Cada uma dessas fases pode ser impactada por variações técnicas, humanas ou ambientais. Por isso, acompanhar indicadores laboratoriais ajuda a identificar falhas, promover melhorias contínuas e manter padrões rigorosos de qualidade.
Além disso, o controle de qualidade na embriologia é indispensável para manter a integridade dos processos e oferecer tratamentos mais previsíveis e eficazes. O uso estratégico dos KPIs permite que os laboratórios avaliem sua própria performance, comparem resultados ao longo do tempo e adotem ações corretivas de forma ágil.

A seguir, listamos os principais KPIs utilizados nos laboratórios de reprodução assistida, organizados por categoria.
Essas métricas de sucesso em reprodução assistida são fundamentais para avaliar o desempenho global do laboratório e orientar decisões clínicas.
Coletar dados não é suficiente — é preciso saber como usá-los estrategicamente. Os indicadores devem ser registrados de forma sistemática, analisados com frequência e discutidos com a equipe técnica.
Algumas práticas recomendadas:
Com esse controle, o laboratório se torna mais eficiente, confiável e competitivo — além de oferecer maior segurança ao paciente.

Aliar os KPIs a um sistema robusto de gestão da qualidade é essencial para manter a excelência dos serviços prestados. Entre as boas práticas estão:
Essas ações fortalecem o laboratório e elevam a confiança nos resultados dos tratamentos.

A Ingámed oferece uma linha completa de produtos para laboratórios de reprodução assistida, com qualidade certificada, rastreabilidade e suporte técnico especializado. Desde meios de cultura até consumíveis laboratoriais, nossas soluções são pensadas para garantir desempenho, segurança e padronização em todas as etapas do processo.
Além disso, nossa equipe está pronta para auxiliar laboratórios na implantação de protocolos, treinamentos e boas práticas que favorecem o alcance de melhores indicadores.
Se você busca elevar a qualidade do seu laboratório, fale com nossos especialistas e conheça as soluções que podem transformar seus resultados.
Em um cenário de alta exigência técnica e emocional como o da reprodução humana, os indicadores laboratoriais são aliados indispensáveis para promover a excelência dos serviços prestados. Ao monitorar, interpretar e agir com base nos KPIs, os laboratórios garantem maior controle dos processos, segurança para os pacientes e aumento nas taxas de sucesso dos tratamentos.
A Ingámed acredita que a qualidade é construída com dados, ciência e compromisso. Estamos aqui para apoiar você em cada etapa dessa jornada.